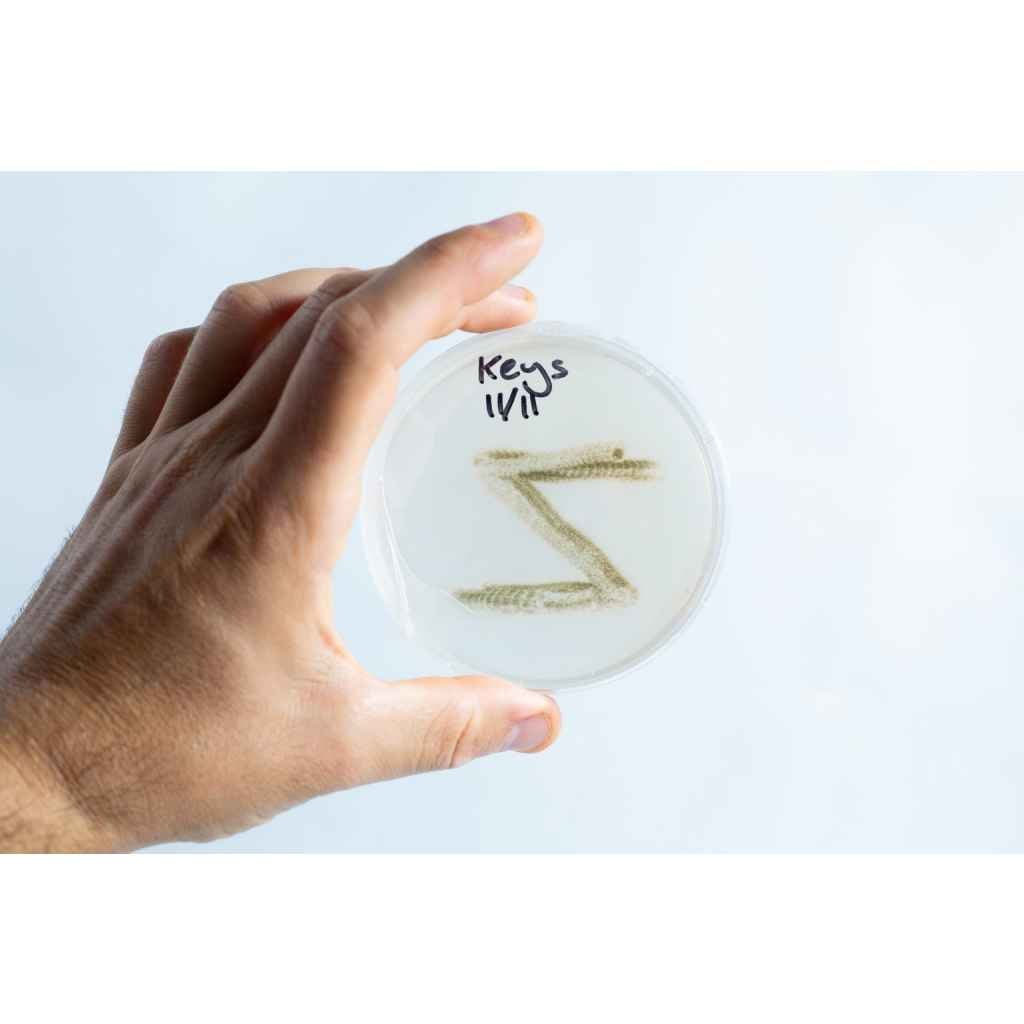

How to Sterilize Liquid Culture Jar in a Microwave?

Making Liquid Culture, it’s a 2-step process. First, make the jar with nutrient medium and then sterilise it. Finally, it is inoculated with mycelium. Steps Step 1 Preparing sterilised Jar (Using microwave technique) Get a desired size jar (Max 1 litre) depending on how much Liquid culture you need to make. The best Jar size […]
How to make Mycelium Objects?

Introduction In this article, we will explore mycelium, the root structure of mushrooms, and use it to create very unique objects. This article will walk you through the essential steps, from preparing the growth medium to the final drying process, to ensure your mycelium object turns out beautiful and robust. Materials Needed Steps a. Selection: […]
Swab and Grow Bacteria Growth Science Experiment
Hurray! You’ve got the coolest parent or science teacher in town! They’ve snagged this super cool microbe science experiment kit for you. Get ready for a journey that’s as educational as it is exciting Presenting your Swab & Grow Microbe Kit Adventure. Let’s dive into the microscopic world! In this kit, you’ll find:• 10 Nutrient-rich […]
How to Grow Cordyceps militaris

Guide to using Rootlab’s cordyceps militaris grow kit This guide and FAQs will assist you in using our kit. Remember that this kit is designed for educational purposes to introduce you to the world of medicinal mushrooms. Always adhere to safety guidelines and do further research where necessary when consuming our cordyceps militaris as tincture […]
Considerations Before Purchasing a Heat Sealer in Australia

The basic heat sealer is a very important device in growing mushrooms. This unsung hero I used to pack and preserve spawn and substrate in bags. It keeps them sterile and safe. Here is what you need to know before purchasing one. Quality Although people like to get great deals, buying a cheap heat sealer […]
Rye or Millet: What’s the Better Grain Choice for Mushroom Cultivation

When producing grain spawn at home, be sure to choose a grain that’s both economical and readily available in your area. Also, you don’t have to overthink your choice. However, you have to consider different factors when buying a pre-sterilized grain bag. Let’s delve into why Millet is often regarded as the gold standard for […]
How to operate All American Sterilizers?

Purchase the complete range of All American electric and non-electric sterilizers. Please note we do not sell pressure cookers or pressure canners; all our products are sterilizers that can reach high temperatures and pressures and maintain them. The model numbers for All American can be quite confusing for some. For instance, All American 1941 is a […]
Complete Guide to Grow Mushrooms in Buckets

Introduction You can easily grow mushrooms at home using buckets, especially if you are using less nutritious substrates and varieties that don’t require complex nutrition for sustenance. Straw and sugarcane mulch are the most commonly used because you can easily pasteurize them by treating them with cold water and Calcium hydroxide. If you want to […]

